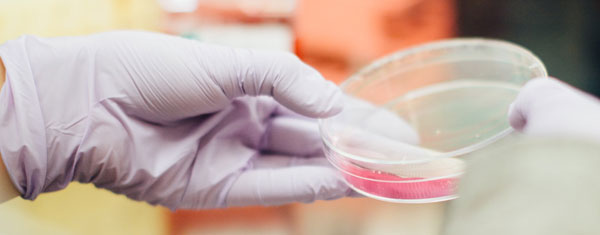

聚焦科研测试,满足个性科研需求,提供快速优质解决方案。
我们的服务
扫码立即咨询 >>


样品随到随测,只发数据,可不出具正式报告。标准周期不超过3个工作日。
提供有竞争力的价格,对标做的较好的民营测试机构。批量化样品及年度套餐协议价格可以更优惠。

全面满足客户的个性化测试需求。测试前过程中测试后随时沟通互动。我们就是客户自身实验室的延伸,可以随时过来现场参与测试(或者视频、云平台等)。

测试工程师具有丰富的该仪器测试经验,处理过各种不同类型的样品。测试工程师具有丰富的新材料专业知识,能深入理解客户的测试目的,测试遇到困难时能 够和客户探讨进一步方案。
自有大型实验室
快速响应客户需求,高效执行,协作共赢
扫码立即咨询 >>

冰火两重天!津巴布韦锂矿断供VS谷歌弃用锂电池,锂电行业遭遇双重夹击2026年2月末到3月初,短短一周时间内,大洋彼岸传来的两则消息,在国内锂电行业掀起了滔天巨浪。2月25日,全球第四大锂矿生产国津巴布韦突然宣布暂停所有锂精矿出口,且恢复时间未定。紧接着,3月初,科技...
11月动力电池产业链解析摘要:2024年的车市旺季超出预期。金九银十已过,但是四季度的旺季态势持续。近日,中汽协数据显示,11月新能源汽车销量达到151.2万辆,同比增长47.4%,环比增长5.7%。1-11月新能源汽车销量...
铁锂、六氟、铜箔涨价率先落地年关将至,由特斯拉、比亚迪、理想汽车等头部整车厂所引领的新能源车价格战再次袭来,引发锂电供应体系关于低价内卷恶性循环的担忧。不过,结合最新2025年价格谈判、市场均价、散单价格跟踪等多重迹象来看,锂电...
扫一扫咨询微信客服